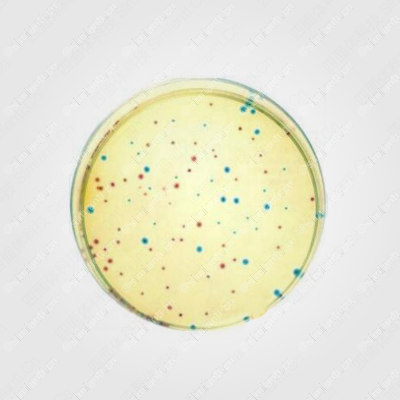

全部商品分类
- 试剂
- 标准物质
-
色谱耗材/配件
通用色谱耗材 液相色谱配件 安全过滤器 喷雾器 液相色谱备件 切换阀及备件 收集器及备品备件 真空脱气机及部件 泵及部件 密封垫 柱塞杆 柱后衍生系统 进样器 工具 柱螺帽 管线 管路切割器 接头 溶剂过滤器配件 在线脱气机 柱温箱 静音罩 检测器灯 放空阀 玻璃过滤头 定量环 PTFE滤芯 入口阀 样品盘 流通池 溶剂过滤器 在线过滤器 溶剂瓶 进样阀 进样针液相色谱柱 F5 毛细管色谱柱 手性柱 其他 合相色谱 保护柱 套装 聚合物柱 多孔石墨碳 体积排阻色谱(SEC) 离子交换柱 专用柱 C3柱 C30柱 Optimix柱 氰基柱 C4 柱 HILIC 柱 C1柱 硅胶柱 C18柱 氨基柱 苯基柱 C8柱气相色谱配件 刃环 离子阱部件和备件 泵油 阀备件 清洗和维护备件 点火器配件 检测器备件 喷嘴 石英管 管线 过滤器及配件 顶空进样器 气体流量计 自动液体进样器部件和备件 接头备件 工具 进样口配件 质谱离子源配件 电子倍增器及备件 灯丝 毛细管接头及配件 柱螺帽 自动进样器 进样针 顶空瓶 衬管 密封垫 O型圈 隔垫气相色谱柱
- 光谱耗材/配件
-
实验室常规耗材
实验室防护用品 过滤制品 纸类制品 四氟制品 金属制品 针头 消毒筐 金属坩埚 燃烧勺 水止夹 坩埚架 三脚架 光管 量杯 滴定夹 取样器 夹子 对顶丝 酒精灯 滴定管架 剪刀 十字夹 接口夹 试管架 打孔器 温度计夹 铁架台 升降台 铁/铝圈 坩埚钳 药刮 药勺 镊子 托盘陶瓷制品 塑料制品 塑料三角瓶 塑料漏斗 酸缸 离心瓶 试验盒 塑料容量瓶 塑料托盘 塑料水槽 比色管架 配重环 一次性巴氏滴管 滴定管头 蒸发皿 试管 血凝板 移液管 废液桶及附件 支架 倾倒环 管 酒精瓶 试剂瓶标签 试剂瓶盖 比色杯 分液管 试管塞 量杯 利器盒 胶带 垫圈 瓶塞 滴定阀 试剂瓶底座 试剂瓶 塑料药勺 储存管 滤芯吸头 移液管架 橡胶塞、翻口塞 塑料量杯 塑料量筒 塑料烧杯 一次性注射器 橡皮筋 封口膜 采样袋 洗耳球 移液器吸头、吸头盒 冻存管 吸管 试管架 离心管 冻存管盒 洗瓶玻璃制品 搅拌棒 砷测定装置 玻璃塞 平皿 自动滴定管 核磁共振管 实验室玻璃瓶 滴定管 洗瓶 蒸发球瓶 温度计套管 合成玻璃器皿 吸管 反应管 反应瓶 三角瓶 恒温玻缸 气体干燥塔 分液器 滴定管头 泵压头 沉淀管 密度瓶 离心管 移液管 酒精计 集气瓶 胶头滴管 比色管 称量舟 盖玻片 温度计 注射器 称量瓶 载玻片 染色缸 酒精灯 层析缸 漏斗 滴瓶 抽滤瓶 干燥器 毛细管 培养皿 层析柱 试剂瓶 坩埚 结晶皿 表面皿 蒸发皿 样品瓶 试管 恒压滴液漏斗 接收管 干燥管 防溅球 分馏头 蒸馏头 冷凝管 分液漏斗 碱式滴定管 酸式滴定管 量杯 量筒 锥形瓶 烧瓶 烧杯 容量瓶生物耗材 采血管 PCR管盒 初级使用仪器 外科手术及实验室配件 手术板套件 血管相关工具 撑开器/牵开器 持针钳及针线 刮勺 针和持针器 铲刀 医用探针和拉钩 止血钳 手术钳及配件 骨工具 手术剪 精细手术剪 弹簧剪 冻存管盖 其他生物耗材 细胞嵌入皿 培养液瓶 细胞推板/涂抹棒 包埋盒 解剖针/镊 昆虫针 细胞筛 刀 样品管/杯 酶标板 培养管 接种环 板盖 深孔板封板垫 PCR管盖 PCR膜 PCR板 PCR管 深孔板 微孔板 培养板 培养瓶 培养皿其它
- 实验室常规设备
- 生命科学仪器
- 行业专用仪器
- 分析仪器
- 办公用品